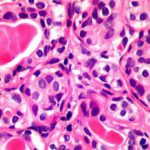

“Edhe një tjetër fitore”, ka komentuar presidenti amerikan, Donald Trump, marrëveshjen për fluturime direkte mes Prishtinës e Beogradit, në arritjen e së cilës kanë qenë të përfshirë direkt zyrtarë amerikanë.
Bashkimi Evropian (BE), i cili ndërmjetëson dialogun mes Kosovës e Serbisë për normalizim të marrëdhënieve, nuk ka qenë i përfshirë në këtë proces, ka mësuar Radio Evropa e Lirë (edicioni në gjuhën serbokroate) nga burime të mirëinformuara brenda institucioneve evropiane. Burimet kanë konfirmuar se zyrtarët evropianë për këtë kanë mësuar përmes mediave, dhe se janë “befasuar” nga kjo informatë, transmeton Koha.net.
Të hënën, një ditë pas nënshkrimit të marrëveshjes, zëdhënësi i shefit të diplomacisë evropiane, Peter Stano, bëri një koment të shkurtër për natyrën “komerciale” të kësaj marrëveshjeje, por vetëm duke iu përgjigjur pyetjes së një gazetari në një konferencë të përditshme për shtyp.
Stano, që është zëdhënës i përfaqësuesit të lartë të BE-së, Joseph Borell, i cili në shumë raste ka deklaruar se do të angazhohet personalisht në dialogun mes Kosovës e Serbisë, marrëveshjen e ka vlerësuar si “sinjal pozitiv”.
“BE-ja mbështet të gjitha lidhjet në rajon që forcojnë komunikimin e njerëzve mes Serbisë e Kosovës. Kjo është një prej mënyrave si të përparohet drejt normalizimit të marrëdhënieve mes Beogradit e Prishtinës”, deklaroi Stano, duke shtuar se hapja e linjës komerciale nuk do të ndikojë apo ndryshojë qëndrimin e BE-së ndaj statusit të Kosovës.
Se kur do të nis ky fluturim 25 minutësh, ende nuk dihet. Nga kompania Lufthansa, avio-kompania e cila nënshkroi marrëveshjen me Kosovën dhe Serbinë, kanë thënë se Eurowings do të jetë fluturimi që do t’i lidhë dy qytetet ndërsa detajet tjera do të publikohen javëve në vijim.